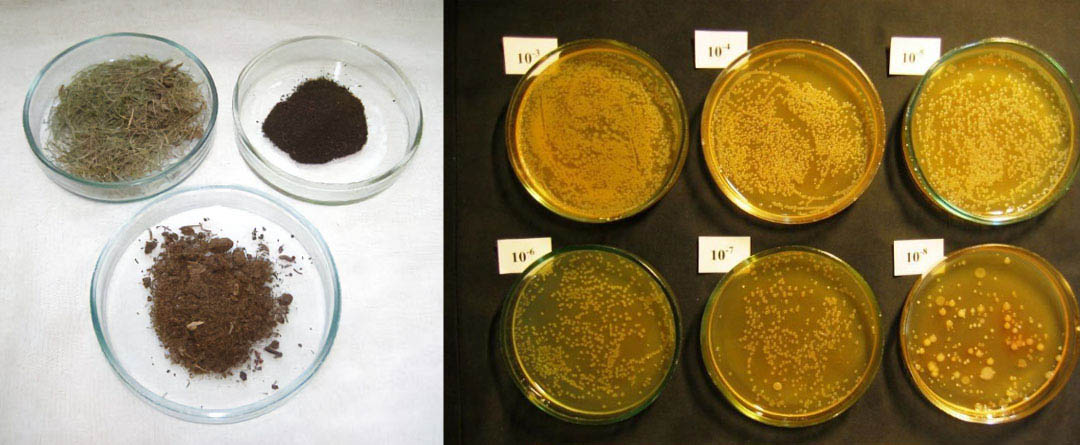
raksta vāka attēls Naftas absorbenti: definīcija un sastāvs

Sliekšņa skimmeris: efektīvs virsmas attīrīšanai
Daudzām nozarēm Latvijā, tostarp rūpniecības uzņēmumiem, ostām un pašvaldību dienestiem, aktuāla problēma ir ūdens virsmas piesārņojums. Šis piesārņojums, ko bieži veido naftas produkti, eļļas, tauki un citi peldoši materiāli, apdraud gan vidi, gan operacionālo efektivitāti un atbilstību normatīviem. Nepieciešami ātri, uzticami un efektīvi risinājumi šī piesārņojuma novēršanai. Šajā rakstā mēs detalizēti izpētīsim, kas ir sliekšņa skimmeris,...
Lentes skimmeris: eļļas savākšanas risinājums
Vairumā ražošanas un apstrādes procesu uzņēmumi saskaras ar nopietnu problēmu: piesārņojumu, ko rada klaiņojošā eļļa, smērvielas un skaidas dzesēšanas šķidrumos vai mazgāšanas vannās. Šis piesārņojums ir kluss ienaidnieks, kas lēnām, bet neatgriezeniski bojā iekārtas, izraisot koroziju, sūkņu bojājumus un filtru aizsērēšanu. Rezultātā samazinās produkta kvalitāte, pasliktinās darba vide, rodas nepatīkamas smakas un ievērojami pieaug izmaksas...
Naftas absorbenti: definīcija un sastāvs
Sākot ar nelielām naftas noplūdēm darbnīcā vai noliktavā līdz potenciāli lielākiem incidentiem rūpnieciskās vidēs vai transporta sektorā, naftas piesārņojums ir nopietna un bieža problēma, kas prasa ātru un efektīvu risinājumu. Nepareiza pieeja šo noplūžu likvidēšanai var radīt ne tikai ievērojamus finansiālus zaudējumus (sodu veidā, dārgas tīrīšanas izmaksas), bet arī apdraudēt darbinieku veselību un drošību, kā...
Naftas ceļvedis: nozīme, tirgus un ietekme
Melnais zelts – pasaules dzinējspēks un izaicinājums Vai esam kādreiz aizdomājušies par naftas klātbūtni mūsu ikdienā? Tā ir neredzama, bet vitāli svarīga mūsu civilizācijas sastāvdaļa, sākot no transporta līdzekļu degvielas līdz pat plastmasas izstrādājumiem. Šajā rakstā mēs aplūkosim naftas daudzveidīgos aspektus – tās veidošanos un ieguvi, tirgus dinamiku, ģeopolitisko nozīmi un vides izaicinājumus. Lasītāji iegūs visaptverošu...